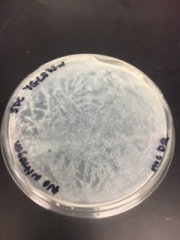

File list
This special page shows all uploaded files.
| Date | Name | Thumbnail | Size | Description | Versions |
|---|---|---|---|---|---|
| 06:18, 25 April 2019 | test plot.png (file) |  |
15 KB | This is a test plot. | 1 |
| 06:26, 25 April 2019 | Calibration Chart.docx (file) | 49 KB | This is the data we collected through testing the absorption in the amount of yeast with different amounts of G-418 | 1 | |
| 06:47, 25 April 2019 | Calibration graphs 5889 image014.png (file) |  |
57 KB | This is the data we collected through testing the absorption in the amount of yeast with different amounts of G-418 | 1 |
| 18:58, 29 April 2019 | ycl002c growth.png (file) |  |
22 KB | Basic growth-rate assay data for a YCL002C knock-out strain. | 1 |
| 19:06, 29 April 2019 | ycr100c growth.png (file) |  |
23 KB | Growth curve for a YCR100C knock-out strain in a BY4735 background. | 1 |
| 19:09, 29 April 2019 | yel035c growth.png (file) |  |
23 KB | Growth curve for a YEL035C knock-out strain in a BY4735 background. | 1 |
| 19:11, 29 April 2019 | yfl064c growth.png (file) |  |
21 KB | Growth curve for a YFL064C knock-out strain in a BY4735 background. | 1 |
| 19:14, 29 April 2019 | ygl235w growth.png (file) |  |
23 KB | Growth curve of a YGL235W knock-out strain in a BY4735 background. | 1 |
| 19:16, 29 April 2019 | yjl043w growth.png (file) |  |
23 KB | Growth curve for a YFJ043W knock-out strain in a BY4735 background. | 1 |
| 19:19, 29 April 2019 | ymr090w growth.png (file) |  |
24 KB | Growth curve of a YMR090W knock-out strain in a BY4735 background. | 1 |
| 19:20, 29 April 2019 | ypl068 growth.png (file) |  |
23 KB | A growth curve of a YPL068C knock-out strain in a BY4735 background. | 1 |
| 05:54, 30 April 2019 | YCR100C growth plate.JPG (file) |  |
96 KB | Growth of YCR100C on synthetic defined media (SDC) for 2 days incubated at 30 degrees Celsius. | 1 |
| 06:00, 30 April 2019 | YHR022C growth plate.JPG (file) |  |
101 KB | Growth of YHR022C on synthetic defined media (SDC) for 2 days incubated at 30 degrees Celsius. | 2 |
| 06:03, 30 April 2019 | YGL235W growth plate.JPG (file) |  |
102 KB | Growth of YGL235W on synthetic defined media (SDC) for 2 days at 30 degrees Celsius. | 1 |
| 06:07, 30 April 2019 | YFL064C growth plate.JPG (file) |  |
107 KB | Growth of YFL064C on synthetic defined media (SDC) for 2 days t 30 degrees Celsius. | 1 |
| 06:10, 30 April 2019 | YJLO43W growth plate.JPG (file) |  |
103 KB | Growth of YJLO43W on synthetic defined media (SDC) for 2 days t 30 degrees Celsius. | 1 |
| 06:12, 30 April 2019 | YMRO90W growth plate.JPG (file) |  |
107 KB | Growth of YMRO90W on synthetic defined media (SDC) for 2 days at 30 degrees Celsius. | 1 |
| 06:15, 30 April 2019 | YCLO02C growth plate.JPG (file) |  |
101 KB | Growth of YCLO02C on synthetic defined media (SDC) for 2 days at 30 degrees Celsius. | 1 |
| 06:17, 30 April 2019 | BY4735 wild type growth plate.JPG (file) |  |
105 KB | Growth of wild type BY4735 on synthetic defined media (SDC) for 2 days at 30 degrees Celsius. | 1 |
| 06:18, 30 April 2019 | YEL035C.JPG (file) |  |
99 KB | Growth of YEL035CC on synthetic defined media (SDC) for 2 days at 30 degrees Celsius. | 1 |
| 06:20, 30 April 2019 | YPL068C.JPG (file) |  |
101 KB | Growth of YPL065C on synthetic defined media (SDC) for 2 days at 30 degrees Celsius. | 1 |
| 06:24, 30 April 2019 | YFL064C starvation plate.JPG (file) |  |
25 KB | Growth of YFL064C on omission media that lacks nitrogen for 5 days at 30 degrees Celsius. | 1 |
| 06:26, 30 April 2019 | YMRO90W starvation plate.JPG (file) |  |
27 KB | Growth of YMRO90W on omission media that lacks nitrogen for 5 days at 30 degrees Celsius. | 1 |
| 06:28, 30 April 2019 | YCR100C starvation plate.JPG (file) |  |
28 KB | Growth of YCR100C on omission media that lacks nitrogen for 5 days at 30 degrees Celsius. | 1 |
| 06:30, 30 April 2019 | wild type BY4735 starvation plate.JPG (file) |  |
26 KB | Growth of wild type BY4735 on omission media that lacks nitrogen for 5 days at 30 degrees Celsius. | 1 |
| 06:31, 30 April 2019 | YJLO43W starvation plate.JPG (file) |  |
28 KB | Growth of YJL043W on omission media that lacks nitrogen for 5 days at 30 degrees Celsius. | 1 |
| 06:32, 30 April 2019 | YGL235W.JPG (file) | |
28 KB | Growth of YGL235W on omission media that lacks nitrogen for 5 days at 30 degrees Celsius. | 1 |
| 06:34, 30 April 2019 | UV 700 seconds and 900 seconds.jpeg (file) |  |
2.4 MB | Stressing wild type yeast at 700 and 900 seconds under 400 watt bulb. | 1 |
| 06:35, 30 April 2019 | YCL022C starvation plate.JPG (file) |  |
28 KB | Growth of YCL022C on omission media that lacks nitrogen for 5 days at 30 degrees Celsius. | 1 |
| 06:38, 30 April 2019 | YEL035C starvation plate.JPG (file) |  |
25 KB | Growth of YEL035C on omission media that lacks nitrogen for 5 days at 30 degrees Celsius. | 1 |
| 06:39, 30 April 2019 | YPL065C starvation plate.JPG (file) |  |
25 KB | Growth of YPL065C on omission media that lacks nitrogen for 5 days at 30 degrees Celsius. | 1 |
| 06:42, 30 April 2019 | UV 500 and 900 Seconds.jpeg (file) |  |
2.42 MB | Stressing wild type yeast at 200 and 500 seconds under 400 watt bulb. | 1 |
| 06:47, 30 April 2019 | HeatShockGrowthCurve.png (file) |  |
12 KB | 1 | |
| 06:47, 30 April 2019 | UV 60 and 100 Seconds.jpeg (file) |  |
2.75 MB | Stressing wild type yeast at 60 and 100 seconds under 400 watt bulb. | 1 |
| 06:50, 30 April 2019 | image002.png (file) |  |
26 KB | 2 | |
| 06:50, 30 April 2019 | image004.png (file) |  |
25 KB | 1 | |
| 06:51, 30 April 2019 | image007.png (file) |  |
22 KB | 1 | |
| 06:51, 30 April 2019 | image008.png (file) |  |
25 KB | 1 | |
| 06:51, 30 April 2019 | image009.png (file) |  |
48 KB | 1 | |
| 06:51, 30 April 2019 | image010.png (file) |  |
50 KB | 1 | |
| 06:51, 30 April 2019 | image011.png (file) |  |
25 KB | 1 | |
| 06:52, 30 April 2019 | image012.png (file) |  |
50 KB | 1 | |
| 06:52, 30 April 2019 | image015.png (file) |  |
25 KB | 1 | |
| 06:52, 30 April 2019 | image014.png (file) |  |
82 KB | 1 | |
| 06:54, 30 April 2019 | YPL068C UV light.jpeg (file) |  |
1.47 MB | 2 | |
| 06:57, 30 April 2019 | image016.png (file) |  |
49 KB | 1 | |
| 06:58, 30 April 2019 | YELO35C Growth in Methanol.png (file) |  |
20 KB | 1 | |
| 11:45, 1 May 2019 | ph.4 Test Condition1.PNG (file) |  |
17 KB | 1 | |
| 12:00, 1 May 2019 | Example.png (file) |  |
12 KB | 1 | |
| 12:20, 1 May 2019 | Raw Data.PNG (file) |  |
38 KB | 1 |